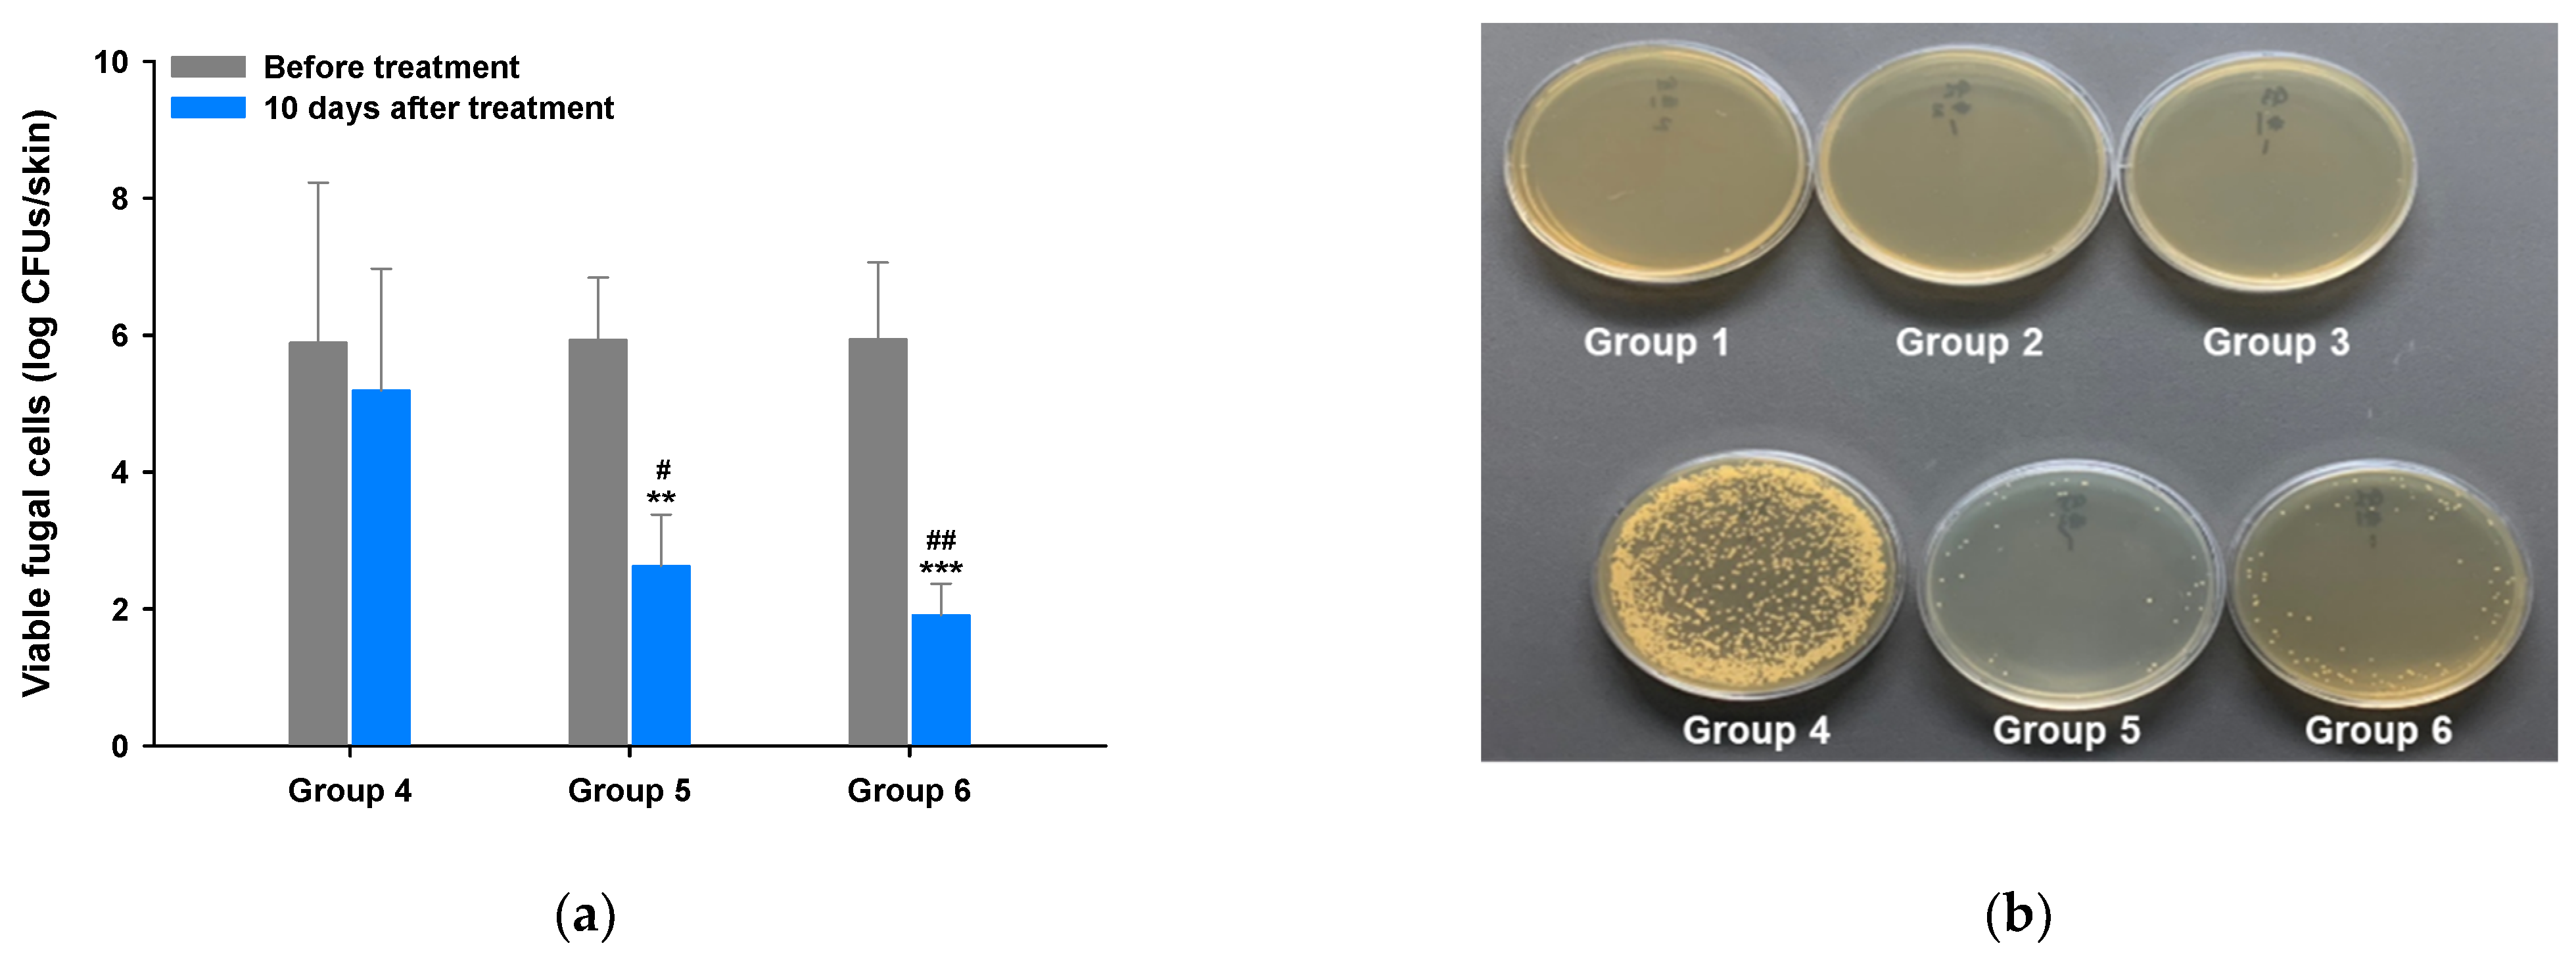
Pharmaceutics 13 00622 g004

Preparation of Topical Itraconazole with Enhanced Skin/Nail Permeability and In Vivo Antifungal Efficacy against Superficial Mycosis
Abstract
1. Introduction
2. Materials and Methods
2.1. Materials
2.2. Animals
2.3. Solubility of ITZ in Topical Formulations
2.4. Preparation and In Vitro Artificial Membrane Permeability of Topical ITZ Formulation
2.5. In Vitro Permeation and Deposition of ITZ in Full-Thickness Human Skin
2.6. In Vitro Human Nail Permeability and Deposition of ITZ
2.7. In Vitro Antifungal Efficacy
2.8. In Vivo Skin Irritation and Antifungal Efficacy of ITZ–TF
2.9. Statistical Analyses
3. Results and Discussion
3.1. Drug Stability and In Vitro Artificial Membrane Permeability of ITZ–TF
3.2. In Vitro Permeation and Deposition of ITZ in Full-thickness Human Skin
3.3. In Vitro Human Nail Permeability and Deposition
3.4. In Vitro Antifungal Activity
3.5. In Vivo Antifungal Activity of ITZ–TF
3.5.1. Evaluation of Symptoms Related to Dermal Fungal Infection
3.5.2. Mycological Assay
3.5.3. Histological Evaluation of Skin
4. Conclusions
Author Contributions
Funding
Institutional Review Board Statement
Informed Consent Statement
Data Availability Statement
Acknowledgments
Conflicts of Interest
References
- Dorr, P. 7.14—Fungi and Fungal Disease. In Comprehensive Medicinal Chemistry II; Taylor, J.B., Triggle, D.J., Eds.; Elsevier: Oxford, UK, 2007; pp. 419–443. [Google Scholar]
- Narang, T.; Bhattacharjee, R.; Singh, S.; Jha, K.; Mahajan, R. Dogra Quality of life and psychological morbidity in patients with superficial cutaneous dermatophytosis. Mycoses 2019, 62, 680–685. [Google Scholar] [CrossRef] [PubMed]
- Sheehan, D.J.; Hitchcock, C.A.; Sibley, C.M. Current and emerging azole antifungal agents. Clin. Microbiol. Rev. 1999, 12, 40–79. [Google Scholar] [CrossRef] [PubMed]
- Vlaminck, K.M.J.A.; Engelen, M.A.C.M. Itraconazole: A treatment with pharmacokinetic foundations. Vet. Dermatol. 2004, 15, 8. [Google Scholar] [CrossRef]
- Como, J.A.; Dismukes, W.E. Oral azole drugs as systemic antifungal therapy. N. Engl. J. Med. 1994, 330, 263–272. [Google Scholar]
- Kolarsick, P.A.J.; Kolarsick, M.A.; Goodwin, C. Anatomy and Physiology of the Skin. J. Dermatol. Nurses Assoc. 2011, 3, 203–213. [Google Scholar] [CrossRef]
- Shin, J.H.; Choi, K.Y.; Kim, Y.C.; Lee, M.G. Dose-dependent pharmacokinetics of itraconazole after intravenous or oral administration to rats: Intestinal first-pass effect. Antimicrob. Agents Chemother. 2004, 48, 1756–1762. [Google Scholar] [CrossRef] [PubMed]
- Zheng, W.-S.; Fang, X.-Q.; Wang, L.-L.; Zhang, Y.-J. Preparation and quality assessment of itraconazole transfersomes. Int. J. Pharm. 2012, 436, 291–298. [Google Scholar] [CrossRef]
- Doncker, P.D.; Pande, S.; Richarz, U.; Garodia, N. Itraconazole: What clinicians should know? Indian J. Drugs Dermatol. 2017, 3, 4–10. [Google Scholar]
- Gupta, A.K.; Nolting, S.; de Prost, Y.; Delescluse, J.; Degreef, H.; Theissen, U.; Wallace, R.; Marynissen, G.; De Doncker, P. The use of itraconazole to treat cutaneous fungal infections in children. Dermatology 1999, 199, 248–252. [Google Scholar] [CrossRef]
- Debruyne, D.; Coquerel, A. Pharmacokinetics of antifungal agents in onychomycoses. Clin. Pharmacokinet. 2001, 40, 441–472. [Google Scholar] [CrossRef] [PubMed]
- Garg, T.; Rath, G.; Goyal, A.K. Comprehensive review on additives of topical dosage forms for drug delivery. Drug Deliv. 2015, 22, 969–987. [Google Scholar] [CrossRef] [PubMed]
- Kim, H.; Jung, S.; Yeo, S.; Kim, D.; Na, Y.C.; Yun, G.; Lee, J. Characteristics of Skin Deposition of Itraconazole Solubilized in Cream Formulation. Pharmaceutics 2019, 11, 195. [Google Scholar] [CrossRef] [PubMed]
- Surber, C.; Knie, U. Metamorphosis of Vehicles: Mechanisms and Opportunities. pH Skin Issues Chall. 2018, 54, 152–165. [Google Scholar]
- Gupta, R.; Dwadasi, B.S.; Rai, B.; Mitragotri, S. Effect of Chemical Permeation Enhancers on Skin Permeability: In silico screening using Molecular Dynamics simulations. Sci. Rep. 2019, 9, 1456. [Google Scholar] [CrossRef]
- Domínguez-Gil Hurlé, A.; Sánchez Navarro, A.; García Sánchez, M.J. Therapeutic drug monitoring of itraconazole and the relevance of pharmacokinetic interactions. Clin. Microbiol. Infect. 2006, 12, 97–106. [Google Scholar] [CrossRef]
- Alam, S.; Iqbal, Z.; Ali, A.; Khar, R.K.; Ahmad, F.J.; Akhter, S.; Talegaonkar, S. Microemulsion as a Potential Transdermal Carrier for Poorly Water Soluble Antifungal Drug Itraconazole. J. Dispers. Sci. Technol. 2009, 31, 84–94. [Google Scholar] [CrossRef]
- Zhang, Q.; Murawsky, M.; LaCount, T.; Kasting, G.B.; Li, S.K. Transepidermal water loss and skin conductance as barrier integrity tests. Toxicol. In Vitro 2018, 51, 129–135. [Google Scholar] [CrossRef] [PubMed]
- Clausen, M.L.; Slotved, H.C.; Krogfelt, K.A.; Agner, T. Tape Stripping Technique for Stratum Corneum Protein Analysis. Sci. Rep. 2016, 6, 19918. [Google Scholar] [CrossRef] [PubMed]
- Lee, B.C.; Pangeni, R.; Na, J.; Koo, K.-T.; Park, J.W. Preparation and in vivo evaluation of a highly skin- and nail-permeable efinaconazole topical formulation for enhanced treatment of onychomycosis. Drug Deliv. 2019, 26, 1167–1177. [Google Scholar] [CrossRef]
- Song, X.; Wei, Y.X.; Lai, K.M.; He, Z.D.; Zhang, H.J. In vivo antifungal activity of dipyrithione against Trichophyton rubrum on guinea pig dermatophytosis models. Biomed. Pharmacother. 2018, 108, 558–564. [Google Scholar] [CrossRef]
- Sriamornsak, P.; Burapapadh, K. Characterization of recrystallized itraconazole prepared by cooling and anti-solvent crystallization. Asian J. Pharm. Sci. 2015, 10, 230–238. [Google Scholar] [CrossRef]
- Bagavatula, H.; Lankalapalli, S.; Vinai, V.; Tenneti, K.; Beeraka, N.M.R.; Bulusu, B.T. Comparative Studies on Solubility and Dissolution Enhancement of Different Itraconazole Salts and Their Complexes. Adv. Pharmacol. Pharm. 2014, 2, 85–95. [Google Scholar] [CrossRef]
- Osborne, D.W.; Musakhanian, J. Skin Penetration and Permeation Properties of Transcutol®-Neat or Diluted Mixtures. AAPS PharmSciTech 2018, 19, 3512–3533. [Google Scholar] [CrossRef]
- Takahashi, H. Action of topical anti-trichophyton agents. Jpn. J. Dermatol. 1972, 82, 421–437. [Google Scholar]
- Hashiguchi, T.; Kodama, A.; Ryu, A.; Otagiri, M. Retention capacity of topical imidazole antifungal agents in the skin. Int. J. Pharm. 1998, 161, 195–204. [Google Scholar] [CrossRef]
- Mura, P.; Faucci, M.T.; Bramanti, G.; Corti, P. Evaluation of transcutol as a clonazepam transdermal permeation enhancer from hydrophilic gel formulations. Eur. J. Pharm. Sci. 2000, 9, 365–372. [Google Scholar] [CrossRef]
- Matsuda, Y.; Sugiura, K.; Hashimoto, T.; Ueda, A.; Konno, Y.; Tatsumi, Y. Efficacy Coefficients Determined Using Nail Permeability and Antifungal Activity in Keratin-Containing Media Are Useful for Predicting Clinical Efficacies of Topical Drugs for Onychomycosis. PLoS ONE 2016, 11, e0159661. [Google Scholar] [CrossRef]
- Bseiso, E.A.; Nasr, M.; Sammour, O.A.; Abd El Gawad, N.A. Novel nail penetration enhancer containing vesicles “nPEVs” for treatment of onychomycosis. Drug Deliv. 2016, 23, 2813–2819. [Google Scholar] [CrossRef]
- Bhatt, V.; Pillai, R. Efinaconazole topical solution, 10%: Formulation development program of a new topical treatment of toenail onychomycosis. J. Pharm. Sci. 2015, 104, 2177–2182. [Google Scholar] [CrossRef]
- Varis, T.; Kivistö, K.T.; Backman, J.T.; Neuvonen, P.J. The cytochrome P450 3A4 inhibitor itraconazole markedly increases the plasma concentrations of dexamethasone and enhances its adrenal-suppressant effect. Clin. Pharmacol. Ther. 2000, 68, 487–494. [Google Scholar] [CrossRef]
- Sha, X.; Yan, G.; Wu, Y.; Li, J.; Fang, X. Effect of self-microemulsifying drug delivery systems containing Labrasol on tight junctions in Caco-2 cells. Eur. J. Pharm. Sci. 2005, 24, 477–486. [Google Scholar] [CrossRef] [PubMed]
- Spósito, P.Á.; Mazzeti, A.L.; de Oliveira Faria, C.; Aurbina, J.; Pound-Lana, G.; Bahia, M.T.; Mosqueira, V.F. Ravuconazole self-emulsifying delivery system: In vitro activity against Trypanosoma cruzi amastigotes and in vivo toxicity. Int. J. Nanomed. 2017, 12, 3785–3799. [Google Scholar] [CrossRef]
- Chellan, G.; Neethu, K.; Varma, A.K.; Mangalanandan, T.S.; Shashikala, S.; Dinesh, K.R.; Sundaram, K.R.; Varma, N.; Jayakumar, R.V.; Bal, A.; et al. Targeted treatment of invasive fungal infections accelerates healing of foot wounds in patients with Type 2 diabetes. Diabet. Med. 2012, 29, 255–262. [Google Scholar] [CrossRef] [PubMed]
- Choi, J.U.; Lee, S.W.; Pangeni, R.; Byun, Y.; Yoon, I.S.; Park, J.W. Preparation and in vivo evaluation of cationic elastic liposomes comprising highly skin-permeable growth factors combined with hyaluronic acid for enhanced diabetic wound-healing therapy. Acta Biomater. 2017, 57, 197–215. [Google Scholar] [CrossRef] [PubMed]

| Formulations (%, w/w) | ITZ | BHA | EDTA | Water | Benzyl Alcohol | HCl | 1 M NaOH | Transcutol P | Cyclomethicone | Ethanol |
|---|---|---|---|---|---|---|---|---|---|---|
| ITZ in ethanol | 1 | 0.1 | 0.0025 | 0.9975 | 97.900 | |||||
| ITZ–TF#1 | 1 | 0.1 | 0.0025 | 0.9975 | 10 | 87.900 | ||||
| ITZ–TF#2 | 1 | 0.1 | 0.0025 | 0.9975 | 20 | 77.900 | ||||
| ITZ–TF#3 | 1 | 0.1 | 0.0025 | 0.9975 | 30 | 67.900 | ||||
| ITZ–TF#4 | 1 | 0.1 | 0.0025 | 0.9975 | 30 | 0.121 | 1.12 | 66.659 | ||
| ITZ–TF#5 | 1 | 0.1 | 0.0025 | 0.9975 | 30 | 0.242 | 2.13 | 65.528 | ||
| ITZ–TF#6 | 1 | 0.1 | 0.0025 | 0.9975 | 30 | 0.484 | 4.12 | 63.296 | ||
| ITZ–TF#7 | 1 | 0.1 | 0.0025 | 0.9975 | 30 | 0.484 | 3.64 | 10 | 53.776 | |
| ITZ–TF#8 | 1 | 0.1 | 0.0025 | 0.9975 | 30 | 0.484 | 3.48 | 15 | 48.936 | |
| ITZ–TF#9 | 1 | 0.1 | 0.0025 | 0.9975 | 30 | 0.484 | 3.46 | 20 | 46.044 | |
| ITZ–TF#10 | 1 | 0.1 | 0.0025 | 0.9975 | 30 | 0.484 | 4.64 | 15 | 5.00 | 47.160 |
| ITZ–TF#11 | 1 | 0.1 | 0.0025 | 0.9975 | 30 | 0.484 | 4.68 | 15 | 8.22 | 39.156 |
| Group | Immunosuppression | Scratching | Fungal Infection | Treatment | Administration Route | Dose of ITZ (mg/kg/day) |
|---|---|---|---|---|---|---|
| 1 | ITZ–TF#11 (vehicle) | Topical | ||||
| 2 | ITZ–TF#11 | Topical | 40 | |||
| 3 | Immuno-suppression | Scratched | ITZ–TF#11 (vehicle) | Topical | ||
| 4 | Immuno-suppression | Scratched | Infected | ITZ–TF#11 (vehicle) | Topical | |
| 5 | Immuno-suppression | Scratched | Infected | ITZ oral capsule | Oral | 40 |
| 6 | Immuno-suppression | Scratched | Infected | ITZ–TF#11 | Topical | 40 |
| Formulation | Initial Drug Concentration (mg/mL) | Drug Content after 1 Month (%) 1 | Cumulative Permeated Drug (µg/mL) 2 |
|---|---|---|---|
| ITZ in ethanol | 0.32 ± 0.01 | 12.7 ± 0.69 | 0.244 ± 0.033 |
| ITZ–TF#1 | 9.25 ± 0.01 | 38.9 ± 0.88 | 1.244 ± 0.120 |
| ITZ–TF#2 | 9.33 ± 0.07 | 51.1 ± 0.30 | 2.560 ± 0.170 |
| ITZ–TF#3 | 9.32 ± 0.95 | 58.4 ± 0.46 | 3.156 ± 0.012 |
| ITZ–TF#4 | 9.24 ± 0.47 | 69.7 ± 0.70 | 3.250 ± 0.150 |
| ITZ–TF#5 | 9.25 ± 0.20 | 80.0 ± 0.46 | 3.420 ± 0.105 |
| ITZ–TF#6 | 9.38 ± 1.65 | 99.5 ± 0.54 | 3.814 ± 0.003 |
| ITZ–TF#7 | 9.41 ± 0.21 | 99.8 ± 1.80 | 11.03 ± 1.465 |
| ITZ–TF#8 | 9.36 ± 0.90 | 99.6 ± 0.15 | 15.59 ± 0.250 |
| ITZ–TF#9 | 9.42 ± 0.11 | 99.8 ± 0.23 | 15.68 ± 0.941 |
| ITZ–TF#10 | 9.40 ± 0.27 | 99.8 ± 1.21 | 24.75 ± 1.384 |
| ITZ–TF#11 | 9.39 ± 0.21 | 99.9 ± 0.60 | 36.65 ± 1.045 |
| Sample | MIC (µg/mL) | MFC (µg/mL) |
|---|---|---|
| ITZ–TF#11 (vehicle) | 50.0 | 100 |
| 1% ITZ in benzyl alcohol | 12.5 | 25 |
| ITZ–TF#11 | 4.68 | 25 |
Publisher’s Note: MDPI stays neutral with regard to jurisdictional claims in published maps and institutional affiliations. |
© 2021 by the authors. Licensee MDPI, Basel, Switzerland. This article is an open access article distributed under the terms and conditions of the Creative Commons Attribution (CC BY) license (https://creativecommons.org/licenses/by/4.0/).
Share and Cite
Subedi, L.; Song, S.-Y.; Jha, S.K.; Lee, S.-H.; Pangeni, R.; Koo, K.-T.; Kim, B.J.; Cho, S.-S.; Park, J.W. Preparation of Topical Itraconazole with Enhanced Skin/Nail Permeability and In Vivo Antifungal Efficacy against Superficial Mycosis. Pharmaceutics 2021, 13, 622. https://doi.org/10.3390/pharmaceutics13050622
Subedi L, Song S-Y, Jha SK, Lee S-H, Pangeni R, Koo K-T, Kim BJ, Cho S-S, Park JW. Preparation of Topical Itraconazole with Enhanced Skin/Nail Permeability and In Vivo Antifungal Efficacy against Superficial Mycosis. Pharmaceutics. 2021; 13(5):622. https://doi.org/10.3390/pharmaceutics13050622
Chicago/Turabian StyleSubedi, Laxman, Seung-Yub Song, Saurav Kumar Jha, Sung-Ho Lee, Rudra Pangeni, Kyo-Tan Koo, Beum Joon Kim, Seung-Sik Cho, and Jin Woo Park. 2021. "Preparation of Topical Itraconazole with Enhanced Skin/Nail Permeability and In Vivo Antifungal Efficacy against Superficial Mycosis" Pharmaceutics 13, no. 5: 622. https://doi.org/10.3390/pharmaceutics13050622
APA StyleSubedi, L., Song, S.-Y., Jha, S. K., Lee, S.-H., Pangeni, R., Koo, K.-T., Kim, B. J., Cho, S.-S., & Park, J. W. (2021). Preparation of Topical Itraconazole with Enhanced Skin/Nail Permeability and In Vivo Antifungal Efficacy against Superficial Mycosis. Pharmaceutics, 13(5), 622. https://doi.org/10.3390/pharmaceutics13050622

